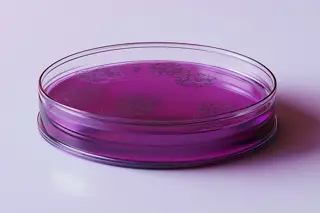
Faecal Streptococci Faecal Streptococci

Our specialised testing solutions are designed to support safe and compliant water systems across diverse industries, including healthcare, manufacturing, hospitality, and building management.
Whether you need regular testing for water safety or specific analysis for compliance, CTS provides precise and actionable results.
Why Water Microbiology Testing is Essential
Water systems are susceptible to microbial contamination, which can impact public health, product safety, and overall environmental and industry regulation compliance.
Routine water microbiology testing helps detect potentially harmful microorganisms that can proliferate in water systems, especially where water stagnates or conditions are suitable for bacterial growth.
CTS's water microbiology testing services help mitigate these risks, ensuring safe and compliant water systems.

Comprehensive Testing for a Safer Environment
Our water microbiology testing includes a wide range of critical assessments, each designed to identify specific bacteria or microorganisms that can harm health and operational integrity. We utilise advanced testing techniques and adhere to strict industry standards to ensure accurate, reliable results every time.

Legionella Testing
Legionella bacteria, especially Legionella pneumophila, can lead to severe illnesses like Legionnaires' disease. Regular testing for Legionella is essential for facilities with complex water systems, including cooling towers, hot water systems, and fountains. Our Legionella testing follows all compliance guidelines, helping you ensure a safe environment.

BSRIA Compliance Testing
For organisations following BSRIA (Building Services Research and Information Association) standards, we offer BSRIA-compliant testing focused on maintaining water hygiene in building services. This testing is crucial for ensuring the safety and efficiency of water systems within commercial and public buildings.

Total Viable Count (TVC)
The Total Viable Count test estimates the microbial population within a water sample. TVC testing is useful for routine monitoring, helping detect changes in water quality that could indicate bacterial growth.

Coliform and E. coli Testing
Coliform bacteria and Escherichia coli (E. coli) indicate faecal contamination, posing significant health risks. Testing for these bacteria is essential, especially in potable water systems, to prevent the spread of waterborne diseases.

Pseudomonas Detection
Pseudomonas bacteria, including Pseudomonas aeruginosa, are common in water and can cause infections, particularly in healthcare settings. Our testing identifies these pathogens to help you implement timely mitigation measures.

Nitrate-Reducing Bacteria (NRB)
Nitrate-reducing bacteria can alter water chemistry, impacting industrial processes and infrastructure. Our testing identifies these bacteria, aiding in proactive system management.

Sulphate-Reducing Bacteria (SRB)
Sulphate-reducing bacteria contribute to corrosion and system damage. SRB testing is crucial for sectors where water quality affects infrastructure, such as industrial water systems.
Faecal Streptococci
Testing for faecal streptococci is crucial as these bacteria indicate recent faecal contamination, which may contain harmful pathogens. Regular testing supports water safety and quality assurance.

Clostridium perfringens
Clostridium perfringens can survive in water longer than other contaminants, serving as a reliable indicator of contamination over time. Testing for this bacteria helps verify long-term water safety.

Salmonella Species Testing
Salmonella bacteria can cause severe foodborne illnesses if present in water systems that contact food or food-related environments. Our testing services detect Salmonella species, enabling targeted treatment and system improvement.
CTS also offers testing for additional parameters, including pH levels, ammonia, fluoride, bromide, various metals, Sulphate-Reducing Clostridia, and more, to further support comprehensive water and soil monitoring programs. Our extended testing options provide a holistic view of environmental quality, helping you maintain compliance and safety across all aspects of water and soil management.
Benefits of CTS's Water Microbiology Testing
CTS's water microbiology testing services offer numerous benefits:
- Accurate Results - Our laboratory is equipped with the latest technology to provide high-precision results.
- Regulatory Compliance - We ensure that all tests meet industry standards, including BSRIA, Health and Safety Executive (HSE) guidelines, and other regulatory requirements.
- Fast Turnaround - We understand the importance of timely results, and our efficient testing process supports quick turnaround times.
- Expert Support - Our team of water quality experts is available to discuss your results and provide actionable advice to enhance water system safety.
Industries We Serve
CTS's water microbiology testing services cater to various industries:
- Healthcare: Hospitals, clinics, and care facilities where waterborne infections must be prevented.
- Manufacturing: Facilities with extensive water systems that require regular safety assessments.
- Hospitality and Leisure: Hotels, spas, and swimming pools need regular monitoring to protect their guests.
- Public Buildings: Schools, offices, and government facilities with public water access points.

Why Choose CTS?
At CTS, we are committed to quality, safety, and customer satisfaction. With extensive industry experience and a dedicated team of professionals, we are well-positioned to meet all your water microbiology testing needs. Our focus on compliance and precision means you can trust our services to deliver reliable, actionable insights.
Contact CTS today to learn more about our water microbiology testing services and how we can help you maintain safe and compliant water systems.
New Water Microbiology Website Coming Soon!
